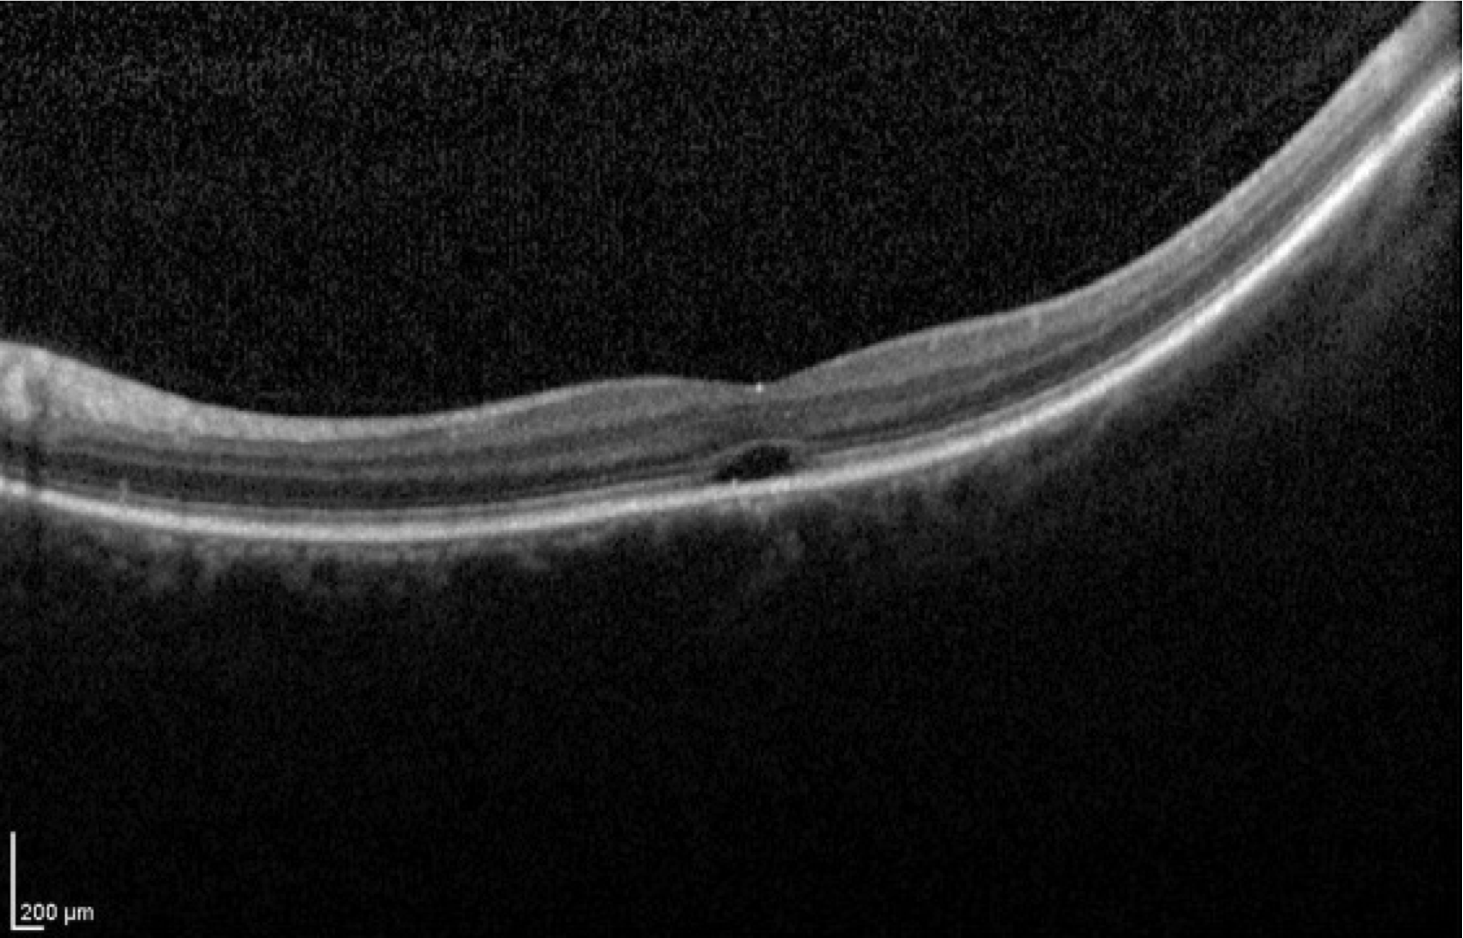

Big 14 Self-Assessment
Case 16
Case 16 is a 47 year old woman who has 20/125 acuity. She has never had acuity better than 20/100. Her normally sighted parents noticed that she did not look at their faces normally or follow toys when she was just 12 weeks of age. Later she had an electroretinogram that revealed normal scotopic responses but extinguished photopic responses. Even as a child, she could not recognize any of the Ishihara plates or name the colors of common objects. She has been photophobic her whole life but could see the same as her friends in very dim environments like playing flashlight tag.